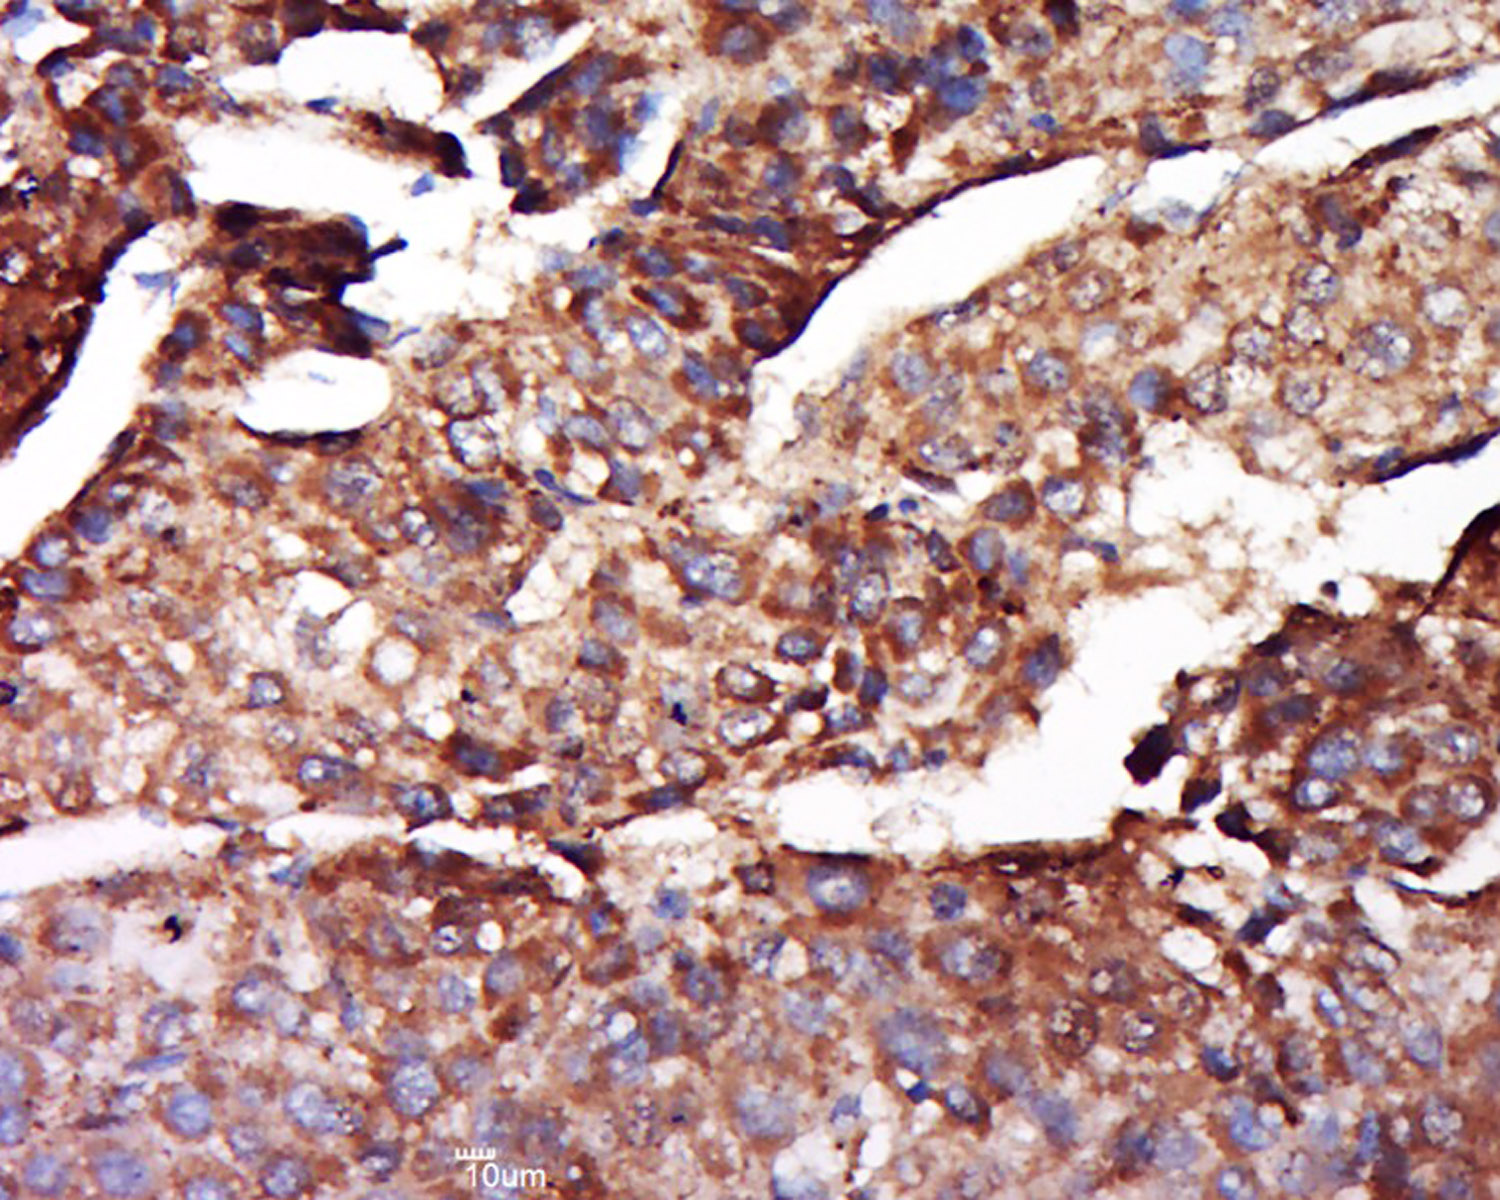
产品细节图片1

相关产品推荐更多 >
万千商家帮你免费找货
0 人在求购买到急需产品
- 详细信息
- 文献和实验
- 技术资料
- 应用范围:
产品信息以Bioss网站为准
- 规格:
50ul/100ul/200ul
| 规格: | 50ul | 产品价格: | ¥1180.0 |
|---|---|---|---|
| 规格: | 100ul | 产品价格: | ¥1980.0 |
| 规格: | 200ul | 产品价格: | ¥2800.0 |
| 产品编号 | bs-8679R |
| 英文名称 | Ferritin Heavy Chain Rabbit pAb |
| 中文名称 | 铁蛋白重链抗体 |
| 英文别名 | Apoferritin; Cell proliferation inducing gene 15 protein; F HC; Ferritin H subunit; Ferritin heavy chain; Ferritin heavy polypeptide 1; FHC; FRIH; FTH 1; FTH; FTH1; FTH1 protein; FTHL 6; FTHL6; Iron overload autosomal dominant; MGC104426; OK/SW-cl.84; PIG 15; PIG15; Placenta immunoregulatory factor; PLIF; Proliferation inducing gene 15 protein; Proliferation inducing protein 15; FRIH_HUMAN. |
| 产品应用 | IHC-P=1:100-500, IHC-F=1:100-500, IF=1:100-500 Not yet tested in other applications. |
| 交叉反应 | Human (Mouse, Rat, Chicken, Dog, Cow, Horse, Rabbit, Sheep) |
| 抗体来源 | Rabbit |
| 免疫原 | KLH conjugated synthetic peptide derived from human Ferritin Heavy Chain |
| 亚型 | IgG |
| 性状 | Liquid |
| 纯化方法 | affinity purified by Protein A |
| 克隆类型 | Polyclonal |
| 理论分子量 | 21 kDa |
| 浓度 | 1mg/ml |
| 储存液 | 0.01M TBS (pH7.4) with 1% BSA, 0.02% Proclin300 and 50% Glycerol. |
| 研究领域 | Cardiovascular > Blood > Serum Proteins Metabolism > Pathways and Processes > Cofactors, Vitamins / minerals > Vitamins / minerals Metabolism > Types of disease > Neurodegenerative disease Neuroscience > Neurology process > Neurodegenerative disease > Alzheimer's disease Signal Transduction > Metabolism > Vitamins / Minerals |
| 亚基 | Oligomer of 24 subunits. There are two types of subunits: L (light) chain and H (heavy) chain. The major chain can be light or heavy, depending on the species and tissue type. The functional molecule forms a roughly spherical shell with a diameter of 12 nm and contains a central cavity into which the insoluble mineral iron core is deposited. |
| 亚细胞定位 | Cytoplasmic. |
| 组织特异性 | In human liver the heavy chain is the major chain. |
| 相似性 | Belongs to the ferritin family. Contains 1 ferritin-like diiron domain. |
| 功能 | Stores iron in a soluble, non-toxic, readily available form. Important for iron homeostasis. Has ferroxidase activity. Iron is taken up in the ferrous form and deposited as ferric hydroxides after oxidation. Also plays a role in delivery of iron to cells. Mediates iron uptake in capsule cells of the developing kidney. |
| 保存条件 | Shipped at 4℃. Store at -20℃ for one year. Avoid repeated freeze/thaw cycles. |
| 注意事项 | This product as supplied is intended for research use only, not for use in human, therapeutic or diagnostic applications. |
| 背景资料 | Mammalian ferritins consist of 24 subunits made up of two types of poly-peptide chains, ferritin heavy chain and ferritin light chain, which each have unique functions. Ferritin heavy chains catalyze the first step in iron storage, the oxidation of FeII, whereas ferritin light chains promote the nucleation of ferrihydrite, enabling storage of FeIII. The most prominent role of mamma-lian ferritins is to provide iron-buffering capacity to cells. In addition to iron buffering, heavy chain ferritin is also involved in the regulation of thymidine biosynthesis via increased expression of cytoplasmic serine hydroxymethyltransferase, which is a limiting factor in thymidylate synthesis in MCF-7 cells. Light chain ferritin is involved in cataracts by at least two mechanisms: hereditary hyperferritinemia cataract syndrome, in which light chain ferritin is overexpressed; and oxidative stress, an important factor in the development of aging-related cataracts. |
| 应用 | 推荐稀释比例 |
| {IHC-P} | {1:100-500} |
| {IHC-F} | {1:100-500} |
| {IF} | {1:100-500} |
Antigen retrieval: citrate buffer ( 0.01M, pH 6.0 ), Boiling bathing for 15min; Block endogenous peroxidase by 3% Hydrogen peroxide for 30min; Blocking buffer (normal goat serum,C-0005) at 37℃ for 20 min;
Incubation: Anti-FHC Polyclonal Antibody, Unconjugated(bs-8679R) 1:500, overnight at 4°C, followed by conjugation to the secondary antibody(SP-0023) and DAB(C-0010) staining
风险提示:丁香通仅作为第三方平台,为商家信息发布提供平台空间。用户咨询产品时请注意保护个人信息及财产安全,合理判断,谨慎选购商品,商家和用户对交易行为负责。对于医疗器械类产品,请先查证核实企业经营资质和医疗器械产品注册证情况。
文献和实验[IF={{ 5.62 }}] {Bingyu Li. et al. cGAS-STING pathway aggravates early cerebral ischemia-reperfusion injury in mice by activating NCOA4-mediated ferritinophagy. EXP NEUROL. 2023 Jan;359:114269} {IF} {Mouse}
[IF={{ 3.1 }}] {Tian Xiaorong. et al. Heme Oxygenase-1-Modified BMMSCs Activate AMPK–Nrf2–FTH1 to Reduce Severe Steatotic Liver Ischemia–Reperfusion Injury. DIGEST DIS SCI. 2023 Sep;:1-16} {IHC,IF,WB} {Rat}
Generation of Rabbit Immune Libraries
for the combinatorial cloning of the variable heavy and light chain immunoglobulin repertoire of rabbits for the subsequent phage display of rabbit scFv antibody fragments is described.
resolution. A detailed protocol of RT-TDPCR is presented here with examples of its use with ribonuclease T1 in mammalian cells for detecting (1) RNA structure and protein footprints of the human ferritin heavy-chain messenger RNA and (2) in vivo structure
by staining in simple IHC the relevant heterologous primary antibodies. E.g. many goat anti mouse IgG1 heavy chain do stain rat IgG2a and IgG2b . Procedure: First stain HRP Developing solution Second stain AP
技术资料暂无技术资料 索取技术资料








